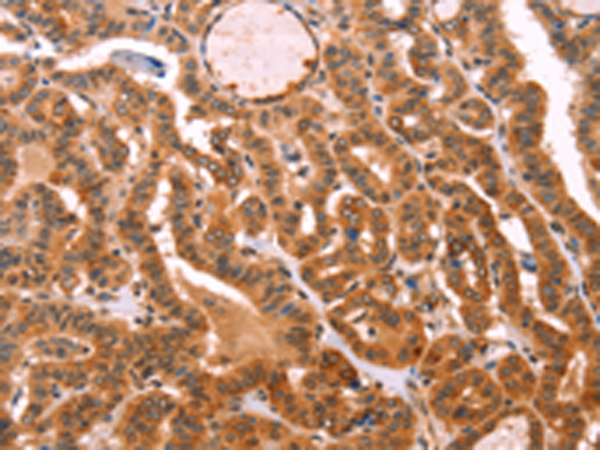
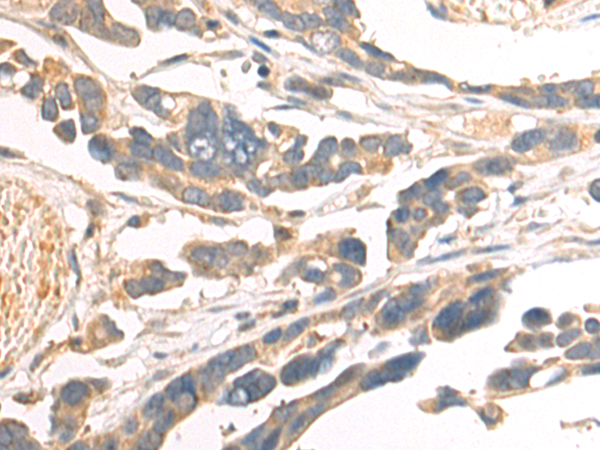
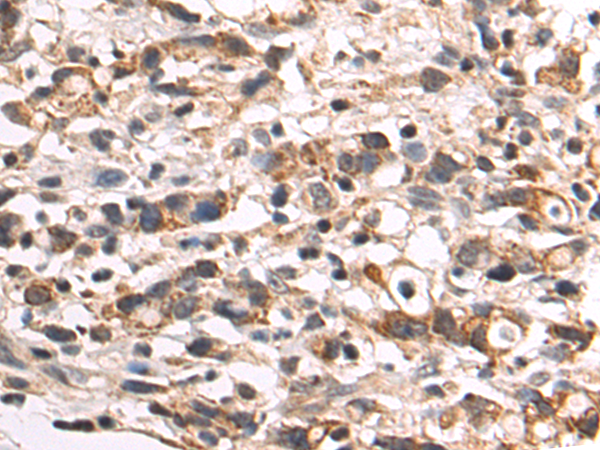
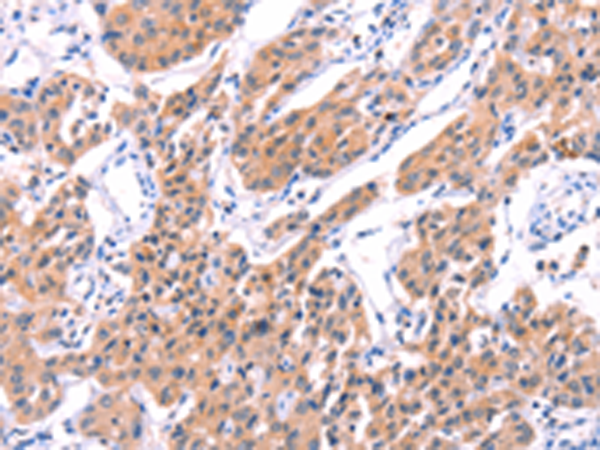

-
分类: 科研抗体货号: P07679别名: RNF84; MGC:39780应用: IHC反应种属: Human, Mouse
-
分类: 科研抗体货号: P07698别名: CMM8; OCA1A; OCAIA; SHEP3应用: WB,IHC反应种属: Human, Mouse
-
分类: 科研抗体货号: P07714别名: PSA; PROS; PS21; PS22; PS23; PS24; PS25; THPH5; THPH6应用: IHC反应种属: Human
-
分类: 科研抗体货号: P07697别名:应用: WB,IHC反应种属: Human, Mouse
-
分类: 科研抗体货号: P07712别名: NR1I1; PPP1R163应用: IHC反应种属: Human, Mouse, Rat
-
分类: 科研抗体货号: P07696别名: LGR3; CHNG1; hTSHR-I应用: IHC反应种属: Human
-
分类: 科研抗体货号: P07709别名: BMR2; PPH1; BMPR3; BRK-3; T-ALK; BMPR-II应用: IHC反应种属: Human, Mouse
-
分类: 科研抗体货号: P07695别名: TSG10; VPS23应用: IHC反应种属: Human, Mouse, Rat
-
分类: 科研抗体货号: P07706别名: FHL5; UNC18B; Hunc18b; UNC18-2; pp10122; MUNC18-2应用: WB,IHC反应种属: Human, Mouse, Rat
-
分类: 科研抗体货号: P07727别名: LYS2; LYS5; CGI-80; AASD-PPT应用: WB,IHC反应种属: Human, Mouse, Rat

鄂公网安备42018502007531号
鄂公网安备42018502007531号

